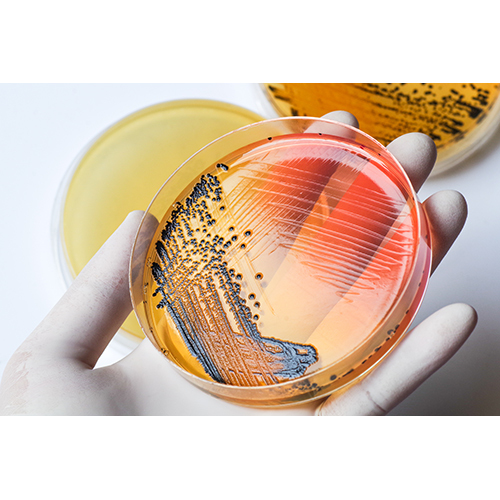
कोई भी रंग आगर आगर बैक्टीरियोलॉजिकल ग्रेड

कोई भी रंग आगर आगर बैक्टीरियोलॉजिकल ग्रेड
प्राइस: 1825.00 INR / Kilograms
(1825.00 INR + 0% GST)नवीनतम कीमत पता करें
स्टॉक में
| दिखावट | Powder |
| गंध | Fruity |
| प्रपत्र | Powder |
| उपयोग | Industrial |
| टाइप करें | Other |
विस्तृत जानकारी
| दिखावट | Powder |
| गंध | Fruity |
| प्रपत्र | Powder |
| उपयोग | Industrial |
| टाइप करें | Other |
| पवित्रता | 98% |
| स्टोरेज | Room Temperature |
| ग्रेड | , Bacteriological Grade |
| रंग | Any Color |
| शेल्फ लाइफ | 3वर्ष |
| डिलीवरी का समय | 7दिन |
| आपूर्ति की क्षमता | 1000प्रति दिन |
| मुख्य घरेलू बाज़ार | All India |
| नमूना उपलब्ध | 1 |
कंपनी का विवरण
मरीन ह्य्द्रोकोलॉइड्स, 1982 में केरल के कोच्चि में स्थापित, भारत में जायके और खाद्य योज्य का टॉप निर्माता,निर्यातक,आपूर्तिकर्ता है। मरीन ह्य्द्रोकोलॉइड्स ट्रेड इंडिया के सूचीबद्ध उत्पादों के सत्यापित और विश्वसनीय विक्रेताओं में से एक है। आपूर्ति और व्यापार के अपने व्यापक अनुभव के साथ, मरीन ह्य्द्रोकोलॉइड्स ने उच्च गुणवत्ता आदि के साथ बाजार में अपने लिए एक प्रतिष्ठित नाम बनाया है। ग्राहक केंद्रित दृष्टिकोण पर ध्यान केंद्रित करते हुए, मरीन ह्य्द्रोकोलॉइड्स की अखिल भारतीय उपस्थिति है और पूरे देश में एक विशाल उपभोक्ता आधार को पूरा करता है। मरीन ह्य्द्रोकोलॉइड्स से ट्रेड इंडिया के गुणवत्ता-सुनिश्चित उत्पादों () को थोक में खरीदें।
व्यापार के प्रकार
निर्माता, निर्यातक, आपूर्तिकर्ता
कर्मचारी संख्या
100
स्थापना
1982
कार्य दिवस
सोमवार से शनिवार
जीएसटी सं
32AAEFM5740K1ZB
Certification
ISO:9001-2008
Explore in english - Agar Agar Bacteriological Grade
विक्रेता विवरण
मरीन ह्य्द्रोकोलॉइड्स
जीएसटी सं
32AAEFM5740K1ZB
रेटिंग
3
नाम
जोसफ जैसे
पता
दीपा बिल्डिंग संतो गोपालन रोड, चुल्लिकाल, कोच्चि, केरल, 682005, भारत
गलत विवरण की रिपोर्ट करें































